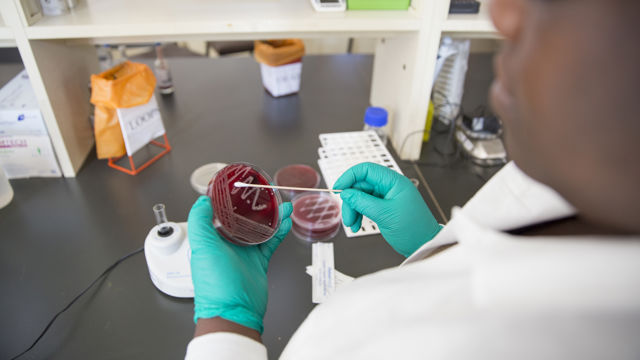

Higher Education and Research
The goal of the portfolio is to contribute to an academic sector in SSA that is able to deliver on its social mission.
Throughout Sub Saharan Africa (SSA), the higher education and research sector struggles to deliver on its social mission - commonly divided into three main tasks: 1) to provide society with a quality workforce 2) to produce research-based knowledge and innovation and 3) to engage with societal actors by sharing knowledge and contributing to debate that inform policies and practices.
The goal of the portfolio is to contribute to an academic sector in SSA that is able to deliver on its social mission. Norad will focus on three outcomes:
- Academic institutions in SSA provide high quality education and research
- Funding to the academic sector in SSA focuses on institutional capacity and local agenda-setting
- Coherence in the academic ecosystem in Tanzania
Please see attached documents for more comprehensive information about the portfolio.